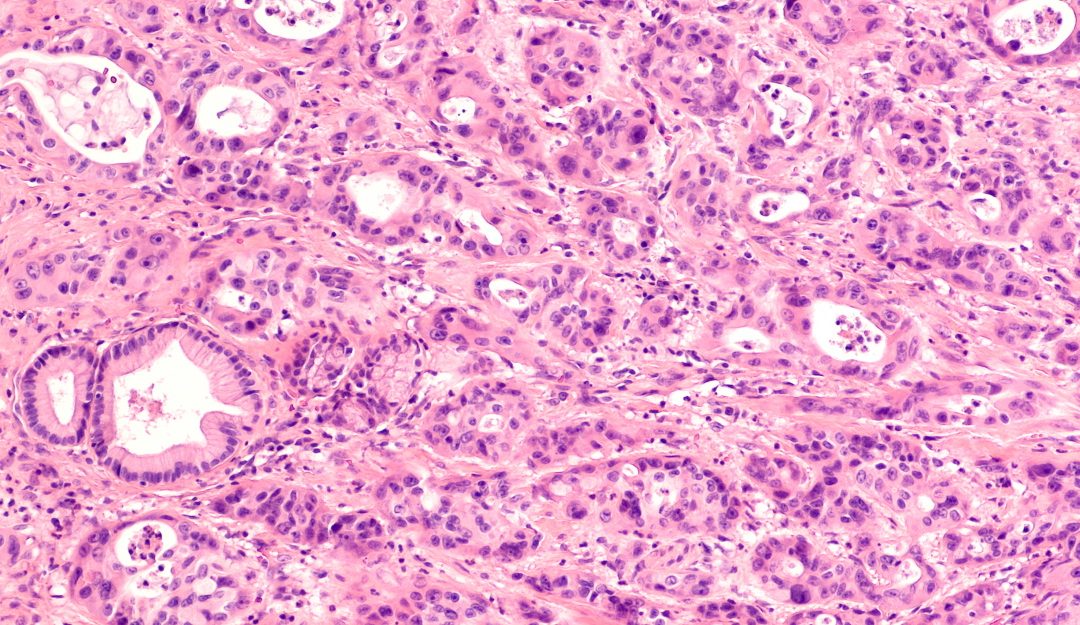
Detecting pancreatic disease using artificial intelligence and human ingenuity

by Admin | Jan 17, 2025 | Blog
What does it take to become an entrepreneur? In this article, Dr Moustafa Haj Youssef and Dr Jahangir Wasim argue that building networks and gaining practical experience is just as important as learning business skills for aspiring entrepreneurs. Learning to be an...

by Admin | Jan 15, 2025 | Articles
Immunology: understanding our body’s defences Published: Immunology plays a critical role in medicine, helping scientists understand allergies, autoimmune disorders, and how the immune system fights infections and cancer. Dr Peter Bretscher, Emeritus Professor of...

by Admin | Jan 14, 2025 | Articles
Detecting pancreatic disease using artificial intelligence and human ingenuity Published: The pancreas is a vital organ for digestion and metabolism, so when issues arise, it is important to diagnose and treat the issue effectively. However, pancreatic diseases are...

by Admin | Jan 9, 2025 | Articles
Celebrating who you are: how clothing shapes LGBTQ+ and feminist weddings Published: How do your clothes make you feel? And why is this important? At the University of British Columbia in Canada, Dr Ilya Parkins is investigating the role that clothing plays in LGBTQ+...

by Admin | Jan 7, 2025 | Articles
The history of hair: tracing its roots to early origins Published: Hair is unique to mammals and has driven mammalian evolution. However, the origins of hair-producing cells, and the genes that code for them, go much further back. Similar genes can be found in a wide...

Recent Comments